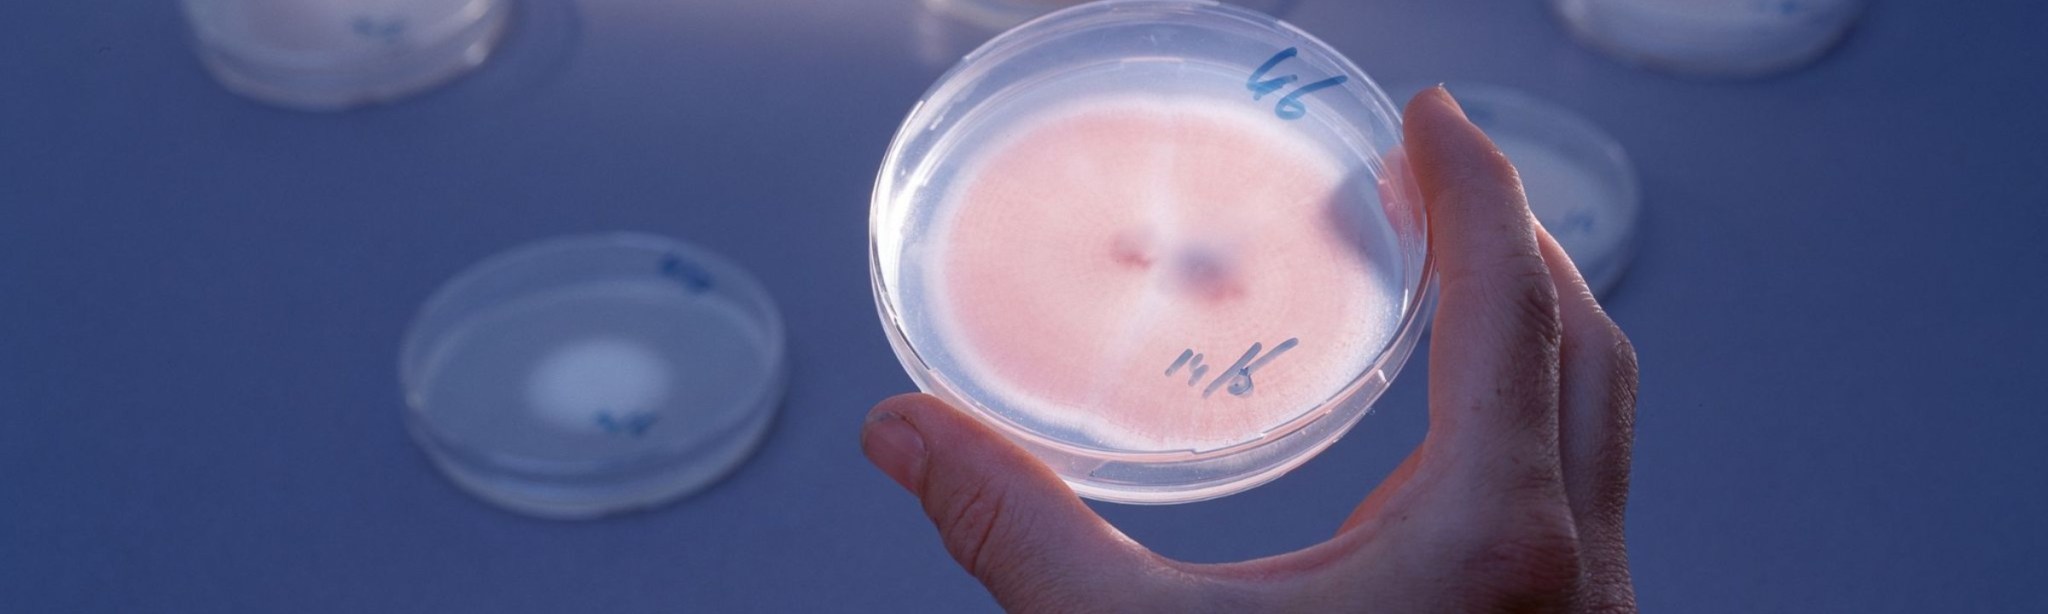

Használja ki a BASF hatóanyagok teljes potenciálját: válassza a BASF formulációit!
Ne hagyja, hogy a gyenge formulációk korlátozzák a sikerét: hozza ki a legtöbbet a BASF hatóanyagokból eredeti, BASF formulációkkal!

A termés sosem pihen. A kórokozók és kártevők sem. De mi sem állunk meg - a cél: a hozampotenciál védelme és az élelmiszer-termelés támogatása.
A növényvédő szerek hatékonyságát gyakran kizárólag a hatóanyaghoz kötjük.
A gyakorlatban azonban a végső teljesítmény legalább ugyanannyira múlik a formuláción: milyen formában jut ki a hatóanyag, hogyan viselkedik a permetlében, és hogyan működik a növényen.
A formuláció az, ami biztosítja, hogy a hatóanyag:
- egyenletesen kijuttatható legyen,
- stabil maradjon,
- jól tapadjon és szétterüljön,
- gyorsan felszívódjon,
- és a környezeti hatásoknak is ellenálljon.
Eredeti formuláció, valódi teljesítmény
Az azonos hatóanyag önmagában nem garancia azonos eredményre. A különbséget a formuláció adja: a stabilitás, a tapadás, a felszívódás és a tartamhatás.
A BASF-formulációi biztosítják, hogy a kijuttatott hatóanyag valóban eljusson oda, ahol hatnia kell.
Miért fektet a BASF kiemelten a formulációk fejlesztésébe?
A BASF évente nettó árbevételének ~10%-át K+F-re fordítja; a modern hatóanyagok – például a Xemium® és a Revysol® – több évtizedes kutatás eredményei. Egy új hatóanyag fejlesztése több, mint 15 év, és ~450 millió euró befektetés. A fejlesztés elején több, mint 140 000 molekula, amely 4 év alatt egyetlen jelöltre szűkül, a legfontosabb kórokozók ellen bizonyítva.
A hatóanyag megszületése után egy újabb, összetett szakasz kezdődik: a formuláció fejlesztése és az engedélyezés.
A BASF formulációs innovációi - a laborból a gyakorlatba
A BASF formulációs kutatásai négy fő területre épülnek:
- Hatóanyag-formuláló laborok
- Hatékonyság optimalizáló laborok
- Kijuttatástechnikai laborok
- Digitális formulálás
A legmodernebb modellezési technológiákkal már a fejlesztés korai fázisában előrejelzik a potenciális stabilitási és kompatibilitási problémákat.
A Revysol®-t tartalmazó termékek (pl. Revyflex®, Revycare®) több variánsból kerültek kiválasztásra: gyors felszívódás, hidegben is erős kuratív hatás, tankkeverék-stabilitás, esőállóság, egyenletes fedettség nagy menetsebességnél.
A formulációfejlesztés a mi kiemelt témánk
Tudjuk, hogyan hozhatjuk ki a legtöbbet hatóanyagainkból:

Mitől jó egy növényvédő szer formulációja?
A jó formuláció egyszerre több kritikus követelménynek kell, hogy megfeleljen.
1) Kijuttathatóság – a csepp, amely célba ér

A permetezés során néhány gramm hatóanyagot kell 10 000 m²-en egyenletesen eloszlatni, változó állományban. Ehhez a készítménynek maradéktalanul oldódnia kell, nem csapódhat ki alacsony hőmérsékleten vagy állás után, és stabilnak kell maradnia eltérő vízminőségek mellett valamint a leggyakoribb tankkeverék partnerekkel.
A BASF a statikus oldhatósági tesztektől a szántóföldi permetezőgépekig valós körülmények közt vizsgálja, hogy a készítmény egyenletesen jusson el a célfelületre.
2) Fizikai és kémiai stabilitás
Szállítástól kijuttatásig a készítmény nem válhat szét, nem ülepedhet, nem kristályosodhat ki – különösen kombinált hatóanyagoknál kulcskérdés a kompatibilitás.
3) Tapadás, terülés és esőállóság

A levélfelületre érkezve a csepp ne pattogjon le, tapadjon meg, terüljön szét, szívódjon fel gyorsan, és beszáradva esőálló filmet képezzen. A BASF nagysebességű kamerákkal elemzi a csepp viselkedést repce- és búzaleveleken; ha kell, a receptúrát tovább finomítja, hogy a legpontosabb fedettséget érje el.
4) Gyors és hatékony felszívódás

A levél viaszrétege kristályos és amorf részekből áll; a kristályos szakaszon a hatóanyagok nehezen jutnak át. A BASF „felvételt segítő” adalékai átmenetileg átrendezik a viaszréteget réteget, növelve az amorf frakció arányát → gyorsabb felszívódás, nagyobb mennyiségű hatóanyag jut a levéllemez belsejébe. Ez egyrészt jobb védelmet jelent az eső és UV ellen.
5) Hatékonyság szélsőséges körülmények között is
Hideg, magas UV-sugárzás, eső előtti/utáni kijuttatás, kemény vagy magas pH-jú víz – a jó formuláció itt is stabil és hatékony. A Revysol® például alacsony hőmérsékleten is kiemelkedő kuratív hatást ad, mert a formulációja gyors bejutást tesz lehetővé, amikor más azolok felszívódása lassul. A már bekövetkezett fertzőzést tehát leállítja.
6) Fenntarthatóság és biztonság
A modern formuláció csak a szükséges hatóanyagot tartalmazza, biztonságosabb a kezelőnek, csökkenti a környezeti terhelést, stabil működést és jobb biológiai hatékonyságot ad. A környezetvédelmi és humán-toxikológiai vizsgálatok szigorúak és többlépcsősek.

„Azonos hatóanyag” ≠ azonos teljesítmény
Kérdés: ugyanazt a „receptet” használták – minden lényegi összetevővel –, és ugyanúgy megfelelően optimalizált gyártással, mégsem nyújtja az elvárt hatékonyságot a növényvédő szer?
Tendencia: Az újabb hatóanyagok egyre kevésbé oldhatóak:

A formuláció pontos összetétele üzleti titok; a generikus gyártók nem férnek hozzá az adjuvánsok/oldószerek/stabilizátorok precíz receptjéhez. A modern hatóanyagok vízoldékonysága nagyságrenddel kisebb a korábbiaknál – megfelelő formuláció nélkül nem várható azonos teljesítmény. Sőt a modern gombaölőszer-hatóanyagok oldatba juttatása és oldatban tartása egyre nehezebb. Olyan régi hatóanyagok oldhatósága, mint a propikonazolé meglehetősen jó volt, mert kevés oldószerrel oldatba lehetett vinni.
Ezzel szemben a modern hatóanyagok – melyek oldószereinek receptúrája üzleti titok –, (pl.: Revysol®, boszkalid) oldatba vitele nehéz, ezért azok utángyártása sem egyszerű. Ez az oka annak, hogy a legújabb készítmények a hatóanyagon kívül nagyrészt adjuvánst, emulgeáló- és oldószereket tartalmaznak, mert csak ez a pontos receptúra garantálja a rendkívül magas hatékonyságot.
Gyakorlati példák (változatlan tények):
- Cantus® stabil marad bekeverés és állás után is, míg egy generikus boszkalid 1 nap után kicsapódhat és eltömítheti a szűrőket/fúvókákat → a hatóanyag egy része el sem jut a növényre.
- 2024-es német vizsgálat: azonos piraklostrobin dózis mellett a Comet™ jobb zászlóslevél-védelmet adott, mint a generikus Tomec®. A Comet® 1997 óta 39 formulációs fejlesztésen ment át, míg a generikus a 2003-as recept tulajdonságait tükrözi.
- Egy generikus azol lehet ~3000 Ft/ha-ral olcsóbb a Revycare®-nél, de egy erős vörösrozsda-fertőzésnél búzában akár 1,8 t/ha termésveszteséget okozhat, így a gazda akár 85 ezer Ft-ot is veszíthet, amit a búza jelenlegi költség és jövedelemviszonyai nem engednek meg.
A Revycare® és a fő azolok, azol-kombinációk sárga- és vörözsrozsda elleni hatékonyságának összevetése őszi búzában

Összefoglalás - válaszd az eredetit
A növényvédő szer hatékonysága nem csak a hatóanyagon múlik. A formuláció dönti el, mennyi, milyen gyorsan és milyen körülmények között jut el a célba és fejti ki a hatását. A BASF formulációs innovációi biztosítják, hogy a hatóanyagból termék, a termékből pedig megbízható megoldás legyen a gazdaságodban.
Hallgassa meg a formulációról szóló Szakmai Ártalom adásunkat:

Formuláció - Amikor a hatóanyagból valódi teljesítmény lesz
A növényvédő szerek kiválasztásakor sokszor a hatóanyag kerül a fókuszba. De vajon tényleg csak ez számít? Ugyanaz a hatóanyag minden esetben ugyanazt a teljesítményt nyújtja? Ebben az adásban a formuláció szerepét járjuk körbe: hogyan lesz a hatóanyagból stabil, kijuttatható és valóban hatékony készítmény.
Beszélünk a különböző formuláció-típusokról, a stabilitás és a penetráció kérdéséről, a levél viaszrétegén való átjutásáról, valamint arról, miért válik egyre fontosabbá a formuláció a fenntarthatóság -, a biztonság - és a piaci körülmények változása mellett.
Kattintson és hallgassa meg:
Kapcsolódó tartalmak:
Eredeti formuláció, valódi teljesítmény
Miért működnek jobban az eredeti BASF megoldások? Mert a hatóanyag mellé az a formuláció kell, amely biztosítja a stabilitást, a tapadást, a gyors felszívódást és a hosszú tartamhatást - vagyis valódi teljesítményt nyújt a gyakorlatban. A BASF formulációi évtizedes kutatómunkára épülnek, és úgy lettek fejlesztve, hogy a hatóanyag a lehető leghatékonyabban jusson el a célba, még változó körülmények között is. Ez az a különbség, amit a generikus megoldások nem tudnak reprodukálni.